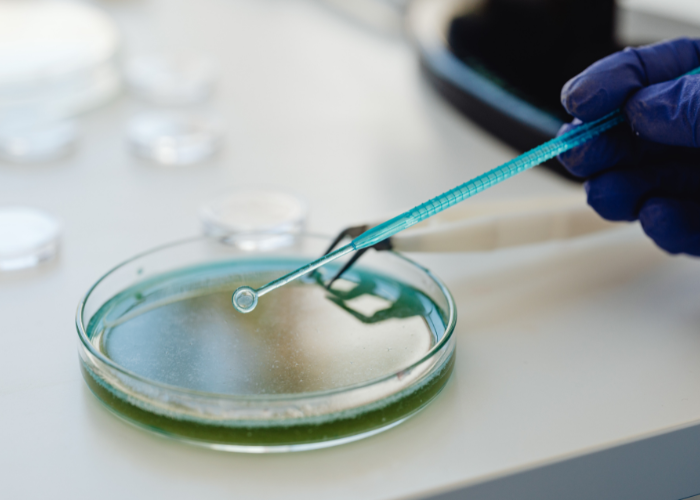

- Improve uneven skin tone and dullness
- Reduce acne, congestion, and mild scarring
- Minimise pigmentation and early fine lines
- Start Your Recovery Today
Your care begins with a doctor’s assessment.
Reveal Smoother, Clearer Skin with Medical-Grade Chemical Peels
Refine skin texture, improve tone, and reduce visible imperfections with doctor-led chemical peel treatment.
What Skin Concerns Can Chemical Peels Address
Chemical Peel treatment is used in the management of:
- Uneven skin tone
- Hyperpigmentation and sun spots
- Melasma
- Acne and clogged pores
- Mild acne scarring
- Rough or dull skin texture
- Fine lines and early ageing signs
See If This Treatment Is Right For You
Consult with our doctor to assess suitability.

Chemical Peel Treatment Overview
Skin can appear dull, uneven, or congested due to dead skin build-up and environmental exposure.
Chemical Peel treatment is a medical aesthetic procedure that uses controlled chemical solutions to exfoliate and renew the skin.
Unlike basic scrubs or home exfoliation, Chemical Peels work at a deeper level to:
- Remove accumulated dead skin cells
- Encourage natural skin regeneration
- Improve clarity, texture, and overall skin appearance
Treatment selection is personalised based on your skin condition and goals.
How Chemical Peel Treatment Works
Chemical Peel treatment works by applying a controlled solution that exfoliates the outer skin layers and stimulates renewal.
This process accelerates cell turnover, allowing newer, healthier skin to replace older damaged skin.
Common technologies and formulations include:
- Alpha Hydroxy Acids (AHA)
Glycolic and lactic acid exfoliate the surface layer to improve brightness and texture - Beta Hydroxy Acids (BHA)
Salicylic acid penetrates pores to manage oil and acne-prone skin - Jessner’s Solution
A combination peel targeting pigmentation and mild acne scarring - Trichloroacetic Acid (TCA)
Used in deeper peels to address more persistent pigmentation and texture concerns
Compared to topical skincare, Chemical Peels are designed to work beneath the surface, allowing more noticeable skin renewal.
Why Choose a Doctor-Led Approach
- Accurate assessment of facial ageing patterns
- Cannula-based techniques to improve safety
- Personalised placement based on anatomy
- Focus on balanced, natural-looking outcomes
Consult with our doctor to assess suitability.

Doctor-Led Assessment
All Chemical Peel treatments are recommended after a medical evaluation.
The doctor will assess:
- Skin type and sensitivity
- Severity of pigmentation or acne
- Current skincare and treatments
- Medical history and suitability
This ensures the treatment type and strength are appropriate for your skin.
Treatment Approach
Chemical Peel treatment may be tailored into different depths:
Light (Superficial) Peel
- Targets the outer skin layer
- Used for mild acne, dullness, and uneven tone
- Can be repeated at intervals
Medium Peel
- Reaches upper dermis
- Used for pigmentation and mild acne scarring
- Requires longer recovery
Deep Peel
- Targets deeper skin layers
- Used in selected cases for deeper wrinkles or pigmentation
- Typically performed once under strict assessment
Book Your Personal Assessment
Personalised care guided by medical expertise.

What to Expect
Consultation
- Skin analysis and treatment planning
Procedure
- Duration: ~20–30 minutes
- Cleansing, application, and controlled removal
- Mild tingling or warmth may be experienced
Duration
- Generally well tolerated
- Sensations are temporary
Aftercare and Recovery
Recovery depends on peel depth.
You may be advised to:
- Avoid sun exposure
- Use gentle skincare and moisturisers
- Apply daily sun protection
- Avoid picking or peeling the skin
Skin renewal occurs gradually over days to weeks.


Possible Side Effects and Risks
Common temporary effects:
- Redness
- Mild swelling
- Dryness or flaking
- Skin sensitivity
Less common risks:
- Post-inflammatory pigmentation
- Prolonged redness
- Infection (rare)
- Scarring (rare)
Following aftercare helps reduce risks.
Suitability
Chemical Peel treatment may not be suitable for individuals who:
- Have active skin infections or severe acne
- Have certain forms of rosacea
- Have known allergies to peeling agents
- Recently underwent other skin procedures
A doctor’s assessment is required to determine suitability.

Why Frances Medical & Aesthetic Clinic
- Established medical clinic since 1977
- Located at Goodwood Park Hotel, Singapore
- Doctor-led diagnosis and treatment planning
- Personalised approach based on skin condition
Treatment recommendations are based on medical assessment and individual needs.
If your skin concerns are persistent or affecting confidence, a medical assessment can help guide appropriate care.
Assessment is required to determine suitability.

